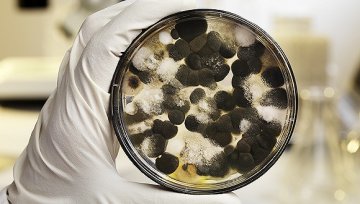
日本乳业公司明治旗下一款风味酸乳被查出霉菌超标九倍

世界上最纯净的牛奶从哪儿来 对于生活在新西兰汉密尔顿郊外的牧场主斯蒂芬而言,每天下午两点钟,雷打不动地,他和他的百余头荷斯坦奶牛等待恒天然公司的奶罐车...
2017-06-29
欧盟食品安全局近日宣布,人工甜味剂善品糖(Splenda)没有致癌风险,先前一项令公众担心善品糖安全性的意大利研究存在缺陷。 意大利拉马齐尼研究所去年...
2017-05-22
2017年4月12日,上海市食品药品监督管理局官网公布2017年第14期省级食品安全监督抽检信息,发现标称明治乳业(苏州)有限公司生产的一款风味酸乳(...
2017-04-21
英国国会议员认为,为了解决儿童肥胖问题,超市应该停止对垃圾食品进行打折。 在周一发布的一份报告中,众议院的健康调查委员会(health select ...
2017-03-30
都说美国人爱喝汽水,但现在他们更爱喝瓶装水了。2016年,美国市场瓶装水的销量第一次超过了碳酸饮料。 根据研究咨询公司Beverage Marketi...
2017-03-13
近日,日本美妆巨头资生堂集团(Shiseido)美国子公司宣布,收购纽约全包式创意公司JWALK,利用后者的尖端创意和数字设计力量支持公司品牌。 资生...
2017-03-10
中国乳业经过8年涅槃,已经具备全面振兴的基础和条件。 2月16日,来自北京的国家奶业科技创新联盟理事长王加启感叹:羡慕福州人,有巴氏鲜奶喝。中国消费者...
2017-03-02
全球最大咖啡连锁星巴克终于准备好进入意式浓缩咖啡(espresso)的发源地意大利。 星巴克计划明年在米兰Piazza Cordusio的一栋百年邮局...
2017-03-02
最新消息称,加拿大百货公司运营商、美国奢侈品百货Saks的母公司Hudsons BayCo(简称HBC)总裁兼执行董事长Richard Baker或将...
2017-02-19
投资商们正在瞄准非洲大陆。尽管一些非洲当地的零售商正遭遇负债等财务压力,投资者的兴趣依然不减。 Nakumatt是现在东非最大的零售商,它刚刚将25%...
2017-01-24
英国每日电讯报发表文章,再次把光明食品收购回来的维多麦(Weetabix)放到聚光灯下。 据该报报道,包括雀巢在内的多个食品巨头正在寻求对这个谷物食品...
2017-01-24
在美国,反感特朗普言论的美国人正在抵制与他和他的家人有业务关系的公司。 上个月涌现了许多抵制运动,其中最突出就是#管好你的钱包(#GrabYourWa...
2017-01-24